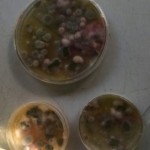

Trabalho de Campo no Museu de História Natural
Terça-feira, 24 de outubro de 2017
Última modificação: Terça-feira, 24 de outubro de 2017
Como parte constituinte das ações didático-pedagógicas de Biologia, pensadas para os estudantes de 1ª e 2ª séries do Ensino Técnico Integrado, a Coordenação de Ciências do Campus BH do CEFET/MG promoveu Trabalho de Campo no Museu de História Natural e Jardim Botânico da UFMG (MHNJB /UFMG) em Junho de 2017. As turmas de Informática, Eletrônica, Eletrotécnica e Edificações, junto a professora de Biologia Leila Saddi Ortega, realizaram diferentes atividades como caminhadas ecológicas, visualização de vida numa gota d’ água, visitação ao viveiro de mudas, análises microbiológicas de água obtida em bromélias, dentre outras. Veja as fotos:

 Serviço de e-mail
Serviço de e-mail